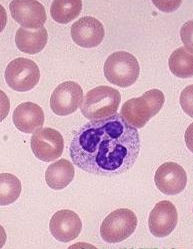
嗜中性粒細胞

描述
嗜中性粒細胞描述:最多,形態不規則,外周常有突起,胞質淡紅色。胞核幼稚型的呈桿狀或馬蹄形,成熟的呈分葉狀,三葉的較多見。
嗜中性粒細胞
嗜中性粒細胞來源
中性粒細胞來源於骨髓的造血幹細胞,在骨髓中分化發育後,進入血液或組織。在骨髓、血液和結締組織的分布數量比是28:1:25,成年人血液中中性粒細胞的數量約占白細胞總數的55%一70%。中性粒細胞屬多形核白細胞的一種,由於其數量在粒細胞中最多,因此有人將多形核白細胞指中性粒細胞。
結構
該細胞內含許多彌散分布的細小的淺紅或淺紫色的特有顆粒,顆粒中含有髓過氧化物酶、酸性磷酸酶、吞噬素、溶菌酶等。髓過氧化物酶是中性粒細胞所特有,即使在有強吞噬作用的巨噬細胞中也極少或完全沒有這種酶。在細胞化學上,一般將這種髓過氧化物酶作為中性粒細胞的標誌。中性粒細胞具有很強的趨化作用。所謂趨化作用,就是細胞向著某一化學物質刺激的方向移動。對中性粒細胞起趨化作用的物質,稱為中性粒細胞趨化因子。中性粒細胞膜上有趨化因子受體,受體與趨化因子結合,激活胞膜上的鈣泵,細胞向前方伸出片足,使細胞移向產生趨化因子的部位。
中性粒細胞的片足與產生趨化因子的異物接觸後,接觸處周圍的胞質形成隆起即偽足,接觸部位的細胞膜下凹,將異物包圍,形成含有異物的吞噬體或吞噬泡。中性粒細胞膜表面有IgGFc受體和補體C3受體,可加速吞噬作用。被吞噬的異物裹有抗體和補體時,與中性粒細胞膜上的相應受體結合,而加強了細胞對它的吞噬作用,稱為調理作用。
細胞隨著吞噬作用的開始,導致細胞膜紊亂而引起呼吸爆發,細胞耗氧量增加,產生大量的過氧化物及超氧化物等細胞毒性效應分子,對寄生蟲具有殺傷活性。在IFN-γ和TNF刺激下,則可產生更多的過氧代謝陰離子,殺死胞外寄生蟲。中性粒細胞在殺死吞噬的細菌等異物後,本身也死亡,死亡的中性粒細胞稱為膿細胞。
中性粒細胞受細菌產物、抗原抗體複合物等作用時,細胞的顆粒內容物向細胞外釋放。釋出的酸性蛋白酶和中性蛋白酶,可以分解血管基膜、腎小球基膜、結締組織的膠原蛋白與彈性蛋白以及血漿中的補體C5、C15和激肽原等。其分解產物有的又是中性粒細跑趨化因子,能吸引更多的中性粒細胞。中性粒細胞釋放的物質中,還有嗜酸性粒細胞趨化因子、中性粒細胞不動因子(NIF)、激肽酶原、血纖維蛋白溶酶原、凝血因子、白三烯等(成令忠,1993)。
作用
除了在抗感染中起重要的防禦作用外,中性粒細胞可引起感染部位的炎症反應並參與寄生蟲感染引發的變態反應,從而引起免疫病理損害。抗體直接作用於組織或細胞上的抗原,中性粒細胞通過其Fc受體與靶細胞表面的IgGFc段結合,發揮ADCC作用,從而導致細胞毒型變態反應損害;當抗原抗體比例適合而形成19S大小的免疫複合物,不易被吞噬,沉積於毛細血管壁,激活補體,吸引中性粒細胞至局部。中性粒細胞通過Fc受體和C3b受體與免疫複合物結合併吞噬之。吞噬過程中脫顆粒,釋放出一系列溶酶體酶類,造成血管和周圍組織的損傷;在IgE介導的速髮型變態反應的部位,也有中性粒細胞的聚集,說明中性粒細胞也參與了速髮型變態反應導致的病理損害(劉約翰等,1993)。
臨床意義
中性粒子細胞增多可初步診斷的病症:急性或化膿性感染、尿毒症、酸中毒、急性出血溶血等。
減少可初步診斷的病症:傷寒、瘧疾、B肝、麻疹、流感、血液病、過敏性休克等。

